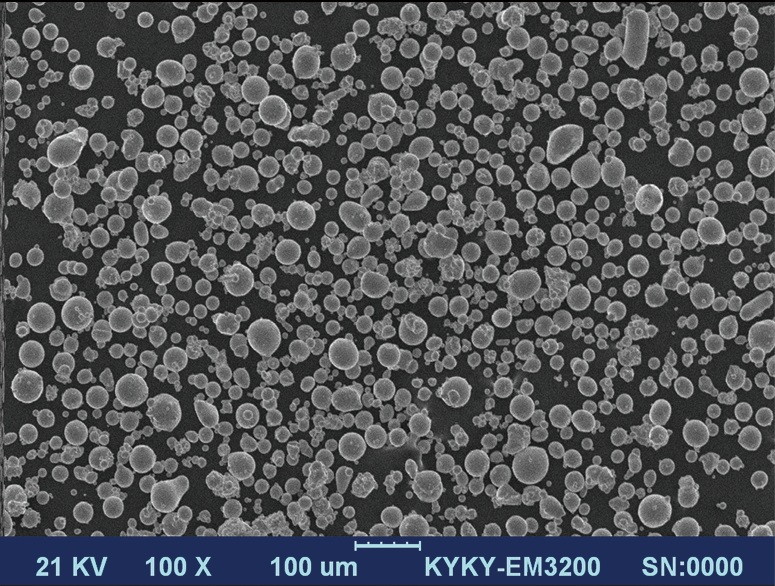
圖片關鍵詞

| Type | CuCrZr | |||||
physical properties | size distribution μm | hall flow s/50g | apparent density g/cm3 | tap density g/cm3 | oxygen content ppm | sphericity % |
| 15-53 | ≤20 | ≥4.4 | ≥5.2 | ≤500 | ≥90 | |
mechanical properties (after heat treatment) | tensile strength MPa | yield strength MPa | elongation % | test temperature | thermal conductivity W/m.k | conductivity % |
| ≥350 | ≥250 | ≥30 | normal | ≥280 | ≥85 | |
| 100℃ | ≥300 | |||||
| SEM | | |||||
-
Your location:
- Home
- > Metal powders
- > Custom alloy



